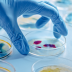
null

Research and Development
At Kivo Lifesciences research and development (R&D) form the cornerstone of our commitment to innovation and excellence in in vitro diagnostics. Our R&D efforts are driven by a passion for scientific discovery, a dedication to improving patient care, and a relentless pursuit of cutting-edge technologies.